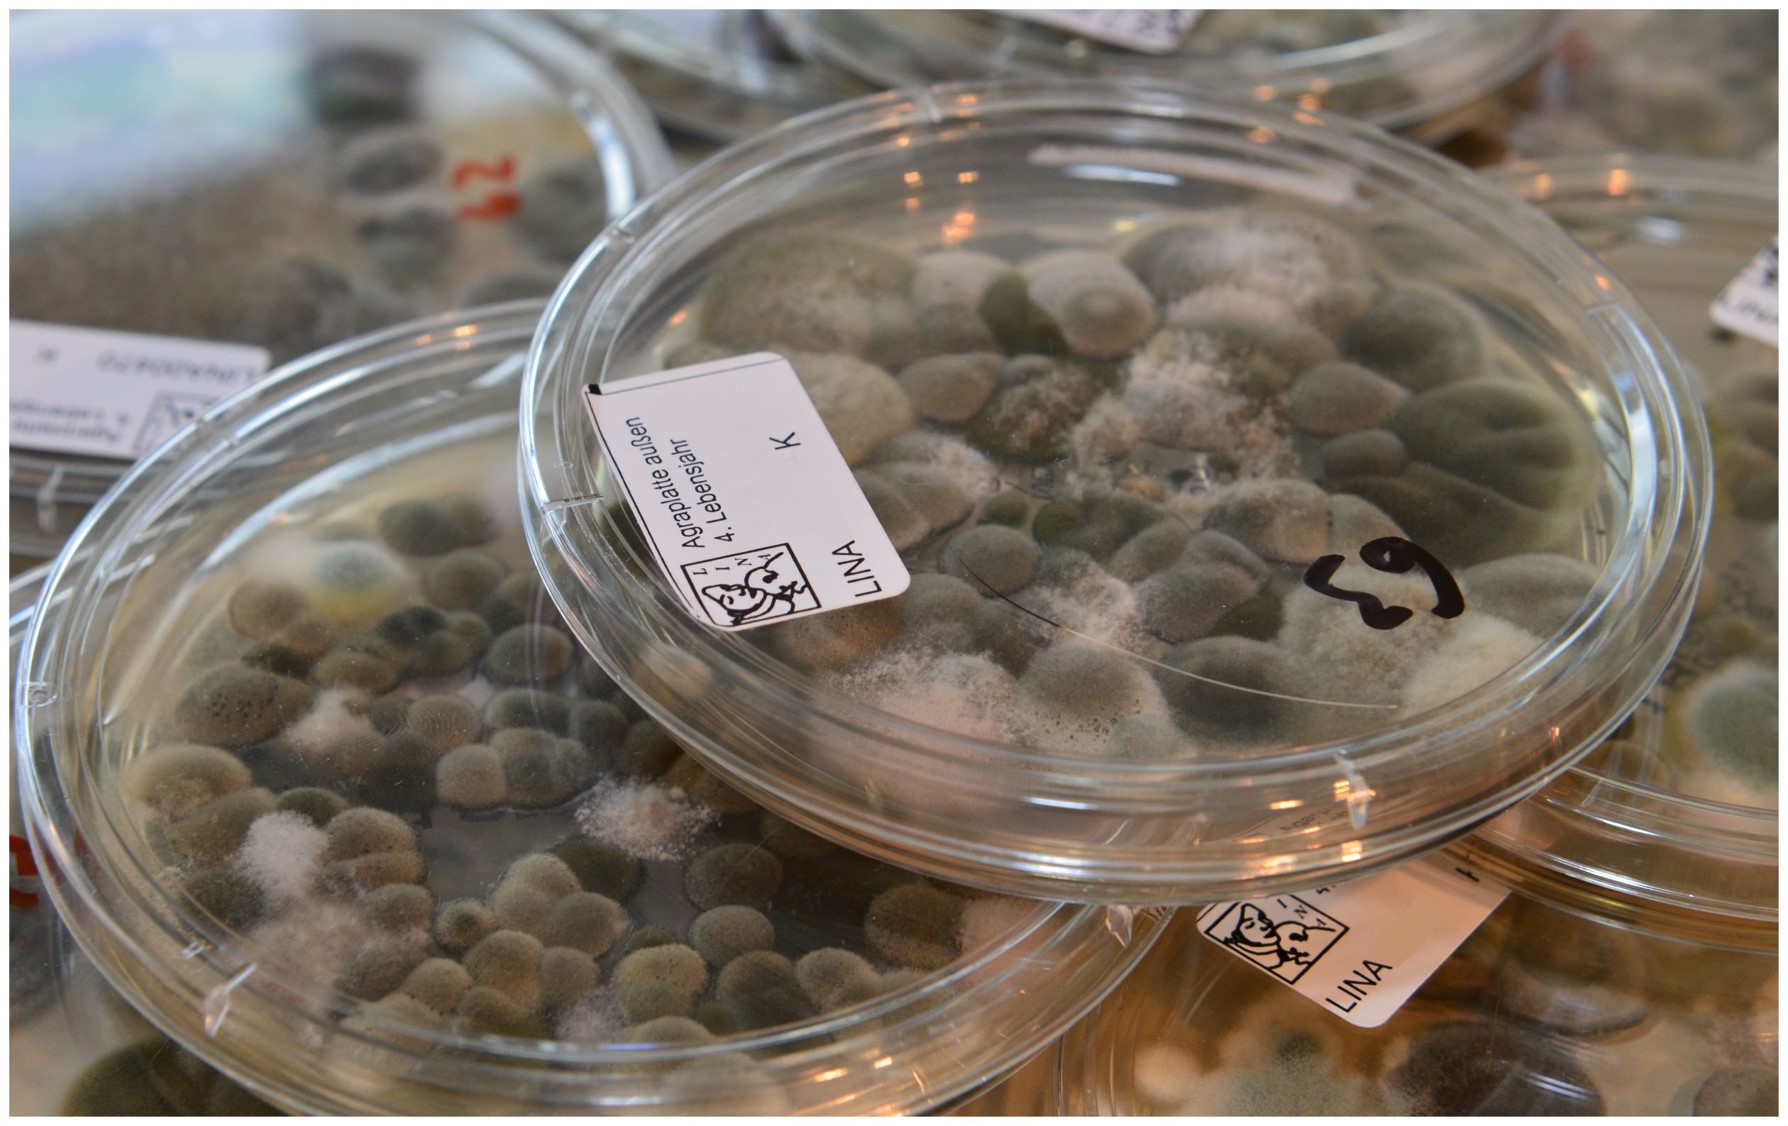

Ihr könnt uns auf der Plattform Bluesky folgen. Dort findet ihr nicht nur Wissenswertes über unsere Arbeitsgruppe, sondern auch alles rund um unsere Forschungsaktivitäten und Publikationen.
 @ufz-immu
@ufz-immu
Projekte
Eine Übersicht der Projekte, in die unser Department zur Zeit involviert ist, findet ihr hier.
Department News
Schon gewusst? Umweltchemikalien können die Hormonfunktionen des Körpers stören. Welche Umweltchemikalien gibt es, welche Bevölkerungsgruppen sind besonders gefährdet und wie kann man sich schützen? Antworten auf diese und weitere Fragen sowie Tipps für einen gesünderen Alltag haben unserer Wissenschaftlerinnen Nicole Meyer und Florence Fischer auf der Seite Umwelthormonchaos und auf Instagram zusammengetragen.
 Foto von Tara Clark auf Unsplash
Foto von Tara Clark auf Unsplash
Diese Woche durften wir Prof. Yankai Xia und Kollegen von der Nanjing Medical University aus China hier am UFZ im Rahmen der Healthy Planet Lecture begrüßen! In seinem Vortrag stellte Prof. Xia innovative Ansätze zur Gesundheitsrisikobewertung bei der Exposition gegenüber Agrochemikalien auf der Grundlage verschiedener Strategien vor. Vielen Dank für den inspirierenden Austausch!
.jpg) v.l.n.r.: Yujie Lui, Dr. Quanquan Guan, Prof. Yankai Xia, Prof. Ana Zenclussen, Prof. Dr. Michael McLachlan
v.l.n.r.: Yujie Lui, Dr. Quanquan Guan, Prof. Yankai Xia, Prof. Ana Zenclussen, Prof. Dr. Michael McLachlan
Herzlichen Glückwunsch an unseren Wissenschaftler Dr. Tobias Kretschmer zum Erhalt des Forschungsstipendiums der Deutschen Gesellschaft für Andrologie (DGA) und der Firma ANDROLABS für sein Projekt "lmmunphänotypisierung und Analyse von Umweltchemikalien im Ejakulat zur Entschlüsselung idiopathischer Ursachen der männlichen Sub- und lnfertilität und den zugrunde liegenden Mechanismen" anlässlich des 11. DvR-Kongresses!
 Links: Michelle Prochazka (Senior Partner und Pharmareferentin bei ANDROLABS), Rechts: Tobias Kretschmer
Links: Michelle Prochazka (Senior Partner und Pharmareferentin bei ANDROLABS), Rechts: Tobias Kretschmer
Foto: Privat
Wir freuen uns, dass das Labor Genexpression der IMMU als erstes Labor am UFZ erfolgreich nach dem LEAF-Standard (Level Bronze) zertifiziert wurde! Unsere tatkräftige technische Assistenz Beate Fink hat in besonderem Maße Engagement gezeigt und bereits viele Maßnahmen umgesetzt. Damit hat sie nicht nur das Bronze-Zertifikat für das Labor erlangt, sondern generell für mehr Nachhaltigkeit im Laborbetrieb des Departments gesorgt!
 Links: Beate Fink, Rechts: Stephan Schreiber
Links: Beate Fink, Rechts: Stephan Schreiber
Foto: Privat
Bei dem 17. Internationalen Kongress für Toxikologie (IUTOX) vom 15. bis 18. Oktober 2025 in Bejing stellte Prof. Ana Zenclussen in der Session Reproductive Toxicity die aktuellen Projekte und Forschungsschwerpunkte unseres Departments vor. Dabei entstanden spannende neue Perspektiven für zukünftige Kooperationen!
 Foto: privat
Foto: privat
Herzlichen Glückwunsch an unseren Wissenschaftler Dr. Sergio Gomez-Olarte zum Erhalt des ITCASS Immunotoxicology, Speciality Section Award für sein Abstract „PFAS mixture effects on single-cell CyTOF-based profiling of human primary immune cells: transitioning to new approach methodologies” auf der EUROTOX 2025 in Athen!
 Foto: privat
Foto: privat
Wir gratulieren Prof. Ana Zenclussen zur Auszeichnung des American Journal of Reproductive Immunology Awards und zur Wahl zur neuen Vizepräsidentin der American Society for Reproductive Immunology (ASRI) und freuen uns über die Würdigung ihrer Arbeit!
Der Preis ist die höchste Auszeichnung, die von der Fachgesellschaft ASRI an eine:n hochrangige:n Forscher:in für herausragende und kontinuierliche Beiträge auf dem Gebiet der Reproduktionsimmunologie verliehen wird.
 Links: Dr. Indira Myrosekar, President of the ASRI, rechts: Dr. Don Torry, Chair of the Prize Committee and former president of the ASRI.
Links: Dr. Indira Myrosekar, President of the ASRI, rechts: Dr. Don Torry, Chair of the Prize Committee and former president of the ASRI.
Foto: ASRI
Wir freuen uns, dass das Review-Paper "The ENDOMIX perspective: how everyday chemical mixtures impact human health and reproduction by targeting the immune system" (Gómez-Olarte et al., 2024) im Journal Biology of Reproduction zum "Editor's Choice" ausgewählt und für die Titelseite der aktuellen Ausgabe hervorgehoben wurde!
Hier geht es zum vollständigen Artikel.
 Foto: https://academic.oup.com/biolreprod
Foto: https://academic.oup.com/biolreprod
Wir koordinieren das EU-geförderte Projekt ENDOMIX.
Wir sind Partner im Projekt Deutsches Zentrum für Kinder- und Jugendgesundheit (DZKJ) und ko-koordinieren den Forschungsbereich Frühe Einflussfaktoren auf Gesundheit und Krankheit.
Wir sind Partner im Verbundprojekt LE-REP.
Wir sind Partner im Verbundprojekt CoViPa.